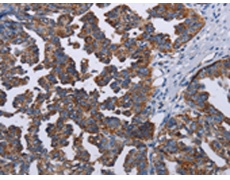
一抗

中文名稱: 兔抗TRIM13多克隆抗體
英文名稱: Anti-TRIM13 rabbit polyclonal antibody
別 名: CAR; LEU5; RFP2; DLEU5; RNF77
相關類別: 一抗
儲 存: 冷凍(-20℃)
抗 原: TRIM13
宿 主: Rabbit
反應種屬: Human, Mouse, Rat
標 記 物: Unconjugate
克隆類型: rabbit polyclonal
技術規(guī)格
|
Background: |
This gene encodes a member of the tripartite motif (TRIM) family. The TRIM motif includes three zinc-binding domains, a RING, a B-box type 1 and a B-box type 2, and a coiled-coil region. This gene is located on chromosome 13 within the minimal deletion region for B-cell chronic lymphocytic leukemia. Multiple alternatively spliced transcript variants have been found for this gene. |
|
Applications: |
ELISA, IHC |
|
Name of antibody: |
TRIM13 |
|
Immunogen: |
Fusion protein of human TRIM13 |
|
Full name: |
tripartite motif containing 13 |
|
Synonyms: |
CAR; LEU5; RFP2; DLEU5; RNF77 |
|
SwissProt: |
O60858 |
|
ELISA Recommended dilution: |
1000-2000 |
|
IHC positive control: |
Human ovarian cancer and human brain |
|
IHC Recommend dilution: |
25-100 |

 購物車
購物車 幫助
幫助
 021-54845833/15800441009
021-54845833/15800441009